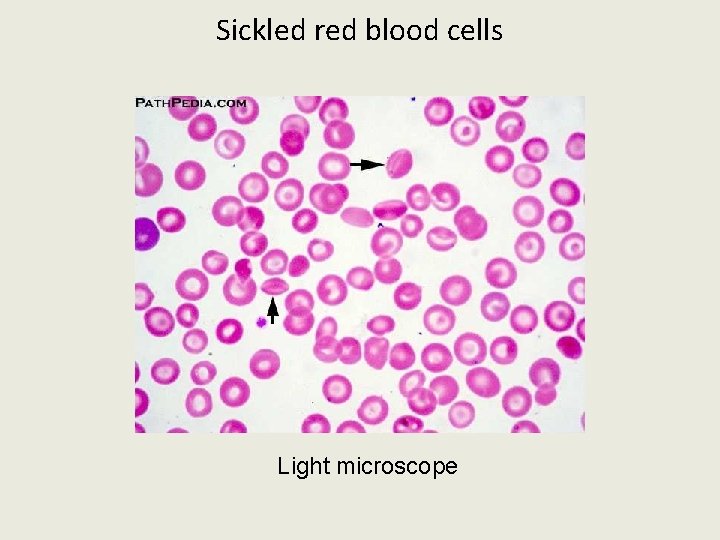
Sickled red blood cells Light microscope

Lesson Overview 2 3 Carbon Compounds Organic and

Lesson Overview 2. 3 Carbon Compounds

Organic and inorganic compounds Organic • Carbon-carbon bonds • With Hydrogen • LARGE, COMPLEX – Ex. Nutrients • Made in living things 4 Main life molecules • • Carbohydrates Lipids (fats) Nucleic acids (DNA) proteins Inorganic • Might have carbon, but NO – Hydrogen – Carbon-carbon bonds – Ex. CO 2 Ca. CO 3 • Small, few atoms • Some are in living things Inorganics needed for life: • Water • Minerals, salts Vitamins are organic, need in small amounts

The Carbon Atom What makes carbon so special? Atomic number _____ valence electrons ____ How many bonds form? Carbon-carbon bonds big, complex structures

Carbon can make large molecules Organic – compounds with at least one carbon atom, and always with hydrogen Carbon can form large, complex structures • Carbon-carbon bonds • chains, branches, rings

Macromolecules Are large molecules (macro) made of smaller units • Form by linking smaller molecules (monomers) together in chains • polymer – long chain of monomers • Chemical process is polymerization • Chemical reaction is dehydration synthesis (or condensation) • All organisms use the SAME MONOMERS!!!

How do monomers link together? DEHYDRATION SYNTHESIS (Condensation) reaction “Put together” by “removing water” Cells synthesize large molecules by linking small molecules together • Each link removes one water molecule ** need enzymes, special molecules that help in all chemical reactions in a cell**

LE 3 -3 a How do monomers link together? Short polymer Unlinked monomer Dehydration reaction Longer polymer New bond formed

How do large molecules break apart? Hydrolysis reaction (Hydro – water; lysis = break) 1. ADD a water molecule – breaks a linking bond 2. Water separates into H atom and OH group 3. These atoms bond to the smaller molecules that form where the link breaks 4. Result two separate smaller molecules **Enzymes needed** • Ex. Lactose intolerance -- lactase enzyme does not break down lactose sugar • Many enzyme names end in -ase

LE 3 -3 b How do large molecules break apart? Water molecule is added Hydrolysis reaction Breaks linking bond

Carbohydrates SUGARS, STARCHES, FIBER • Elements: CARBON, HYDROGEN, OXYGEN (2 H : 1 O) • Functions: mostly for ENERGY ; some for STRUCTURE Monomer: SIMPLE SUGAR or MONOSACCHARIDE • Carbon chain with –OH groups • Can be chain or ring shape - more stable as a ring • Ex. Glucose is a simple sugar

Monosaccharides • Some function alone • Some combine to make larger molecules • most common size: 5 -6 carbons in chain

CARBS – MAIN SOURCE OF ENERGY FOR ALL ORGANISMS GLUCOSE C 6 H 12 O 6 • energy molecule for ALL organisms • Molecule used in cell respiration to make energy • Monomer for all complex carbs STARCH is a large polymer made of glucose

Some shortcuts for drawing organic molecules

Isomers of glucose C 6 H 12 O 6 is also the formula for two other sugars, FRUCTOSE and GALACTOSE same atoms, but different sugar different structure ISOMERS: molecules with the same formula but different shape – Different shape have different properties – **DON’T confuse isomer and isotope. They are two different things!!

Important Monosaccharides ISOMERS: All have the same molecular formula C 6 H 12 O 6 but different structural formula 1. glucose – #1 energy for all organisms • Broken down for energy in cellular respiration • Building unit for all complex carbs, ex. starch 2. fructose – found in fruits, honey, syrup • Has the sweetest taste 3. galactose – part of lactose, the sugar in milk

Disaccharides – double sugars Cells link two single sugars to form disaccharides • dehydration synthesis • For short-term stored energy Glucose Maltose Animation: Disaccharides Many carb names end in -ose Glucose

Important disaccharides • Sucrose: glucose + fructose – “table sugar” – in plant sap – We get it from sugar beets and sugar cane • Lactose: in milk • Maltose : • In seeds, stored food for embryonic plant • Animals make it when they digest complex carbs like starch

LE 3 -7 Polysaccharides = complex carbs Starch granules in potato tuber cells Glycogen granules in muscle tissues Cellulose fibrils in a plant cell wall Cellulose molecules • Polymers of glucose • Link by dehydration synthesis • Long-term stored energy, or structure STARCH Glucose monomer GLYCOGEN CELLULOSE

Storage polysaccharides Starch – storage form of carbs in plants • • Stored in seeds, roots, special cell parts Foods: vegetables, fruits, grains Glycogen – storage form of carbs in animals • In liver and muscle cells • If glucose levels in blood drop, glycogen is changed into glucose Starch granules

Structure polysaccharide- Cellulose • structure and support in plants • in cell walls, wood, paper, cotton, fabrics • Strong and flexible: linked parallel chains Cellulose makes plant cell walls

Lipids – fats, oils, and waxes Elements: carbon, hydrogen, oxygen (less O than in carbs) Functions: stores concentrated energy – Long-term storage – 9 cal/g • more than 2 X calories of carbs (4 cal/g) Nonpolar (no +/- areas) do NOT dissolve in water hydrophobic – “stay away from water”

Other Lipids Functions 1. Cell parts, especially membranes 2. Waterproof coverings (ex. fruits, leaves, feathers) 3. Some hormones (chemical messengers) 4. Transport fat-soluble vitamins (needed in chemical reactions) 5. Insulates (stores heat); padding, 6. Protection – padding, especially around vital organs 7. Lubricates smooth movement in joints

Two lipid monomers 1) Glycerol - 3 carbon chain - each carbon has OH (hydroxyl group) 2) Fatty Acid - Hydrocarbon chain - has carboxyl group on one end - COOH * C-H nonpolar covalent bonds

Lipid monomers join by dehydration synthesis -OH group on each molecule is site for linking bond - Each link makes one water molecule

Triglyceride – common FAT molecule One glycerol + three fatty acids (3 dehydration reactions) - makes 3 water molecules Notice the double bond Molecule bends at this point

Make a triglyceride – dehydration synthesis

To Break Down a Fat 3 hydrolysis reactions • Uses 3 water molecules

Saturated and Unsaturated Fats Saturated fatty acids – “saturated” with hydrogen atoms – All carbon-carbon bonds are single – Solid at room temp, mostly animal fats • Except: coconut and palm oils – Health hazard increases cholesterol in blood

Unsaturated Fats Have one or more Unsaturated fatty acids • One or more double bonds between carbons • Liquid at room temp, most plant oils, fish (omega- 3) • Healthier for humans – less cholesterol forms Monounsaturated Polyunsaturated

Saturated fats pack tightly solid at room temperature Unsaturated fats pack loosely liquid at room temperature

What are “trans fats”? 1. Hydrogen is added to unsaturated fats a. “hydrogenated vegetable oil” b. Makes them more saturated 2. In processed foods, baked goods 3. For texture and taste, longer shelf life 4. Can’t digest raises cholesterol - higher risk of heart disease, diabetes

Food labels list types of carbs and fats

Cholesterol and steroids A different type of lipid Carbon backbone is four joined carbon rings • various chemical groups attached to carbon rings --> Causes different properties cholesterol

Cholesterol – an important steroid • Makes up part of animal cell membranes • Raw material for other molecules – steroid hormones – cortisone and other anti-inflammatories

Other Steroid molecules All have backbone of 4 joined carbon rings Estrogen Testosterone

Why is Cholesterol bad? WHERE DOES IT COME FROM? we make it in our liver we eat it in animal products WHY IS TOO MUCH OF IT UNHEALTHY? If we eat more than we use, excess circulates in the blood Forms a soft, waxy substance called plaque ATHEROSCLEROSIS – fatty deposits inside blood vessels Clogs blood vessels – blocks flow of blood Inside a blood vessel -fatty plaque reduces space

Heart Disease Coronary arteries supply blood to heart muscle Fatty plaques build up inside artery – decreases space for blood to flow Tissues don’t get enough blood ” heart attack”

Angioplasty – a treatment for clogged blood vessels Catheter inside artery, guided to site of blockage Balloon inflated then removed; mesh stent remains

Bypass surgery – detour around clogged blood vessels Restores blood flow to heart muscle

Phospholipids and waxes Phospholipids • Two fatty acids and phosphorus • Main component of cell membranes Waxes • a single fatty acid linked to an alcohol • Form waterproof coatings

Proteins Elements: carbon, hydrogen, oxygen, nitrogen (sometimes sulfur) Monomer: amino acids 3 parts: 1) amino group (NH 2) 2) carboxyl group (COOH) 3) side chain (R group) 20 different R groups

Parts of an amino acid 20 different R groups - make 20 different amino acids

Making a protein polymer Polymer = polypeptide - link many amino acids long, long chains - Dehydration synthesis - Each bond makes a water molecule Peptide bond = between amino acids

Functions of Proteins 1. structure – many cell parts 2. control chemical reactions (enzymes) 3. transport substances (ex. Hemoglobin) 4. fight disease (antibodies) 5. chemical messengers 6. movement (muscles)

Levels of Organization in Proteins A protein's shape determines its function • Made of one or more polypeptide chains folded into a unique shape • “Form follows function” • Must be a specific shape to act on another molecule

Primary structure: the sequence of amino acids – assembled in ribosomes Amino acids Sequence is coded in DNA

More Complex Structure Coiling or folding in parts of the polypeptide chain • Chain folds into a 3 -D shape – Depends on side groups that interact • Two or more polypeptides can be folded together • Hydrogen bonds connect different areas on the molecule

What is a “protein”? • One or more polypeptides folded into a specific, functional 3 -dimensional shape Collagen – in skin, joints hemoglobin – carries oxygen in the blood

How important is protein shape? Normal hemoglobin – in red blood cells, carries oxygen Sickle Cell Disease – abnormal shape of hemoglobin - carries less oxygen cell stress wrinkles clogs tiny blood vessels

Sickled and normal red blood cell Scanning Electron Microscope
Sickled red blood cells Light microscope

Protein Denaturation Denature – lose shape (and function) Chemical or physical changes - break bonds that hold the 3 -D shape Denaturation can be caused by changes in ion concentration, p. H, temperature, and others

Nucleic Acids Elements: Carbon, Hydrogen, Oxygen, Nitrogen and Phosphorus Function: DNA – stores genetic & cell instructions RNA – uses DNA instructions to make proteins Monomer: nucleotide 3 parts: 5 -carbon sugar phosphate group nitrogen base

LE 3 -16 a Parts of a nucleotide Nitrogenous base Phosphate group 5 -carbon Sugar Bases: A – adenine T – thymine C – cytosine G – guanine U - uracil

LE 3 -16 b Nucleic Acid is a nucleotide polymer Nucleotide DNA - Polynucleotide sugar-phosphate backbone nitrogen bases bond to sugars Sugar-phosphate backbone

DNA is two polymers of nucleotides Structure: - Deoxyribose sugar - Hydrogen bonds hold two polymer chains together at A-T and C-G Function: - Base sequence on one chain is a “gene” - Genes direct the amino acid sequence in a protein - One molecule of DNA holds thousands of genes

RNA is a single polymer chain Structure: RNA – ribose sugar Bases: A, C, G, and Uracil Function: Carries a single gene Uses the gene to make a protein ALL ORGANISMS USE THE SAME GENETIC CODE

LE 3 -16 c Base pair

Energy in Chemical Reactions • Life processes are chemical • Need energy added (ACTIVATION ENERGY) to start reactions • Cells cannot use or make heat • ENZYMES speed up reactions – lower activation energy

Enzyme-substrate complex • Substrate – molecule an enzyme acts upon • Active site – region on enzyme molecule that binds to substrate molecule - must fit together!! Active site substrate

How enzymes work Enzymes are “biologic catalysts” catalyst - speeds reaction but is not changed or used up enzymes are specific – act on only one kind of molecule Two models for enzyme action: Induced fit – shape of enzyme changes when substrate attaches Lock-and-key model – perfect fit, no shape change Name – for chemical process or substrate; often end in -ase An anabolic reaction

Enzymes catalyze all reactions A catabolic reaction

Factors Affecting Enzyme Action 3 -dimensional protein molecule - shape is critical Temperature - heat makes molecules move faster more contact between enzyme and substrate faster reaction rate BUT, high temps denature proteins!

Enzymes and p. H Work best at a specific p. H - changes in p. H break bonds holding molecule shape

Enzyme activity and concentration More enzyme or more substrate increase reaction rate - BUT, only up to a point • limiting reactant – all molecules being used

Enzyme Inhibitors Competitive inhibitors - bind to active site - block substrate Noncompetitive inhibitors - change shape of active site by binding somewhere else on the enzyme Feedback inhibitors - a product made in the reaction binds to the enzyme, stops reaction
- Slides: 66